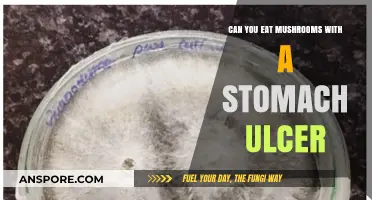
Can You Eat Mushrooms with a Stomach Ulcer? Expert Advice

Eating mushrooms with dark spots can be a cause for concern, as these marks may indicate spoilage, bruising, or the presence of harmful molds. While some dark spots are harmless and simply the result of natural aging or handling, others could signal that the mushroom is no longer safe to consume. It’s essential to inspect the mushroom carefully: if the spots are soft, slimy, or accompanied by an off odor, it’s best to discard them. However, if the spots are firm and the mushroom otherwise appears fresh, it may still be edible. When in doubt, err on the side of caution, as consuming spoiled mushrooms can lead to foodborne illness. Always store mushrooms properly and use them promptly to minimize the risk of developing dark spots.
| Characteristics | Values |
|---|---|
| Edibility | Depends on the mushroom species; some mushrooms with dark spots are edible, while others are toxic. |
| Common Causes of Dark Spots | Bruising, aging, insect damage, or natural pigmentation. |
| Edible Examples | Portobello, shiitake, and some wild mushrooms like chanterelles (if properly identified). |
| Toxic Examples | Certain poisonous species like the Destroying Angel or Death Cap, which may have dark spots due to aging or damage. |
| Safety Precautions | Always identify mushrooms accurately; consult a mycologist or field guide. Avoid consuming mushrooms with dark spots if unsure. |
| Storage Impact | Dark spots can indicate spoilage in stored mushrooms, especially if accompanied by sliminess or off odors. |
| Cooking Effect | Cooking may not neutralize toxins in poisonous mushrooms with dark spots. |
| General Rule | When in doubt, throw it out. Do not consume mushrooms with dark spots unless positively identified as safe. |
Explore related products
$7.61 $8.95
What You'll Learn
- Causes of Dark Spots: Bruising, aging, or environmental factors like sunlight exposure can cause dark spots on mushrooms
- Safety Concerns: Dark spots may indicate spoilage or harmful bacteria, so inspect carefully before consuming
- Edible Varieties: Some mushrooms naturally have dark spots; research specific types to ensure they are safe
- Storage Tips: Proper storage in a cool, dry place can prevent dark spots from forming on mushrooms
- Preparation Advice: Trim or discard dark spots before cooking to minimize potential risks and improve taste

Causes of Dark Spots: Bruising, aging, or environmental factors like sunlight exposure can cause dark spots on mushrooms
Mushrooms, like any living organism, are susceptible to changes that manifest as dark spots. These spots can be a result of bruising, a common occurrence when mushrooms are handled or transported. The delicate flesh of mushrooms can easily be damaged, leading to the rupture of cells and the release of enzymes that cause discoloration. This process is similar to what happens when an apple or banana is bruised, but in mushrooms, it often appears as dark brown or black spots. While bruising doesn’t necessarily render the mushroom inedible, it’s a sign that the mushroom’s texture and flavor may be compromised. For instance, a bruised button mushroom might become softer and less crisp, making it less ideal for salads but still suitable for cooking in soups or sauces.
Aging is another natural cause of dark spots on mushrooms. As mushrooms mature, their cells undergo oxidative stress, leading to the accumulation of melanin-like pigments. This is particularly noticeable in varieties like shiitake or portobello, where older specimens often display darker patches. Aging doesn’t always indicate spoilage, but it does signal a shift in the mushroom’s characteristics. Older mushrooms tend to have a chewier texture and a more intense, earthy flavor. If you’re using them in recipes where texture is less critical, such as blending them into a sauce or stuffing, aged mushrooms with dark spots can still be perfectly edible and flavorful.
Environmental factors, especially sunlight exposure, play a significant role in the development of dark spots on mushrooms. Mushrooms naturally produce melanin as a protective mechanism against UV radiation. When exposed to sunlight, this process accelerates, causing the mushroom’s surface to darken. This is why wild mushrooms often have darker caps compared to their cultivated counterparts, which are typically grown in controlled, low-light environments. While this darkening is a natural defense mechanism, it doesn’t affect the mushroom’s safety for consumption. However, prolonged exposure to sunlight can lead to drying and toughening of the mushroom’s flesh, making it less palatable.
Understanding the causes of dark spots on mushrooms can help you make informed decisions about their use. Bruised mushrooms, for example, are best consumed quickly or cooked to mask any textural changes. Aged mushrooms with dark spots can be repurposed into dishes where their intensified flavor is an asset. Mushrooms with sunlight-induced darkening are safe to eat but may require rehydration if they’ve dried out. By recognizing these causes, you can minimize waste and maximize the potential of mushrooms in your kitchen, ensuring both safety and creativity in your culinary endeavors.
Slow Cooking Porcini Mushrooms: Tips, Techniques, and Delicious Recipes
You may want to see also

Safety Concerns: Dark spots may indicate spoilage or harmful bacteria, so inspect carefully before consuming
Dark spots on mushrooms can be a red flag, signaling potential spoilage or bacterial growth. These marks often appear as mushrooms age or are exposed to moisture, creating an environment conducive to decay. While not all dark spots are dangerous, they warrant careful inspection. Spoilage bacteria, such as *Pseudomonas* or *Bacillus*, thrive in damp conditions and can produce toxins harmful if ingested. Even if the mushroom isn’t poisonous, consuming spoiled fungi can lead to foodborne illnesses like nausea, vomiting, or diarrhea. Always err on the side of caution: if the spots are widespread, soft, or accompanied by a slimy texture or off odor, discard the mushroom immediately.
Inspecting mushrooms for dark spots requires a methodical approach. Start by examining the surface under bright light, looking for discoloration that appears sunken, wet, or fuzzy—these are signs of mold or bacterial growth. Gently press the area; if it feels mushy or releases liquid, it’s likely spoiled. For button or cremini mushrooms, dark spots near the stem base are particularly concerning, as this area retains moisture. In contrast, small, dry spots on the cap may be harmless bruising. When in doubt, cut away the affected area and cook the remaining mushroom thoroughly, as heat can kill some surface bacteria. However, this isn’t foolproof, so trust your instincts.
The risk of harmful bacteria on mushrooms with dark spots increases with storage time and conditions. Fresh mushrooms should be consumed within 5–7 days of purchase, stored in a paper bag in the refrigerator to maintain dryness. Pre-sliced or washed mushrooms spoil faster due to increased moisture exposure, so inspect these more rigorously. Foraging wild mushrooms adds another layer of risk, as dark spots could indicate toxins from environmental contaminants or parasitic growth. If you’re unsure about a wild mushroom’s safety, consult an expert or avoid it entirely. Remember, proper storage and timely consumption are your best defenses against bacterial growth.
While some dark spots may seem minor, they can escalate quickly, especially in humid environments. For instance, a single damp spot on a portobello mushroom can spread within 24 hours, rendering the entire fungus unsafe. Cooking won’t always neutralize toxins produced by bacteria like *Clostridium botulinum*, which thrives in anaerobic conditions. To minimize risk, avoid eating mushrooms with dark spots if you’re immunocompromised, pregnant, or preparing food for young children or the elderly, as these groups are more susceptible to foodborne illnesses. When handling mushrooms, wash your hands and utensils thoroughly to prevent cross-contamination, ensuring safety extends beyond the inspection itself.
Using Hard Mushrooms: Safety, Benefits, and Culinary Tips Explained
You may want to see also

Edible Varieties: Some mushrooms naturally have dark spots; research specific types to ensure they are safe
Not all mushrooms with dark spots are created equal. While some varieties boast natural markings that are perfectly safe to consume, others may indicate spoilage or even toxicity. The key lies in understanding which species naturally develop these spots and learning to differentiate them from potentially harmful lookalikes. For instance, the Shiitake mushroom often displays dark spots on its cap, a characteristic that is entirely natural and does not affect its edibility. These spots are a result of its growth process and are not a sign of decay. Conversely, mushrooms like the Conocybe filaris, which can resemble edible varieties, may develop dark spots as they age, but these spots are a red flag, as this species is toxic.
To safely enjoy mushrooms with dark spots, start by researching the specific type you’re examining. Field guides, reputable online resources, and mycological societies are invaluable tools for identification. For example, the Oyster mushroom may develop darker patches due to bruising or exposure to light, but these changes are harmless. However, if you’re foraging, always cross-reference your findings with multiple sources, as misidentification can have serious consequences. A useful tip is to carry a portable mushroom identification guide or use a trusted app like *PictureThis* or *iNaturalist* for on-the-spot verification.
When in doubt, err on the side of caution. Even if a mushroom appears similar to an edible variety, subtle differences in gill structure, spore color, or habitat can indicate a toxic species. For instance, the Chanterelle mushroom is prized for its golden color and fruity aroma, but it can sometimes develop darker areas due to environmental factors. These changes are safe, but a similar-looking species like the Jack-O’-Lantern mushroom (which is toxic) may also have dark spots, making precise identification critical. If you’re new to foraging, consider joining a local mycological club or attending a workshop to gain hands-on experience under expert guidance.
Finally, remember that cultivation can reduce the risk of encountering harmful mushrooms. Many edible varieties, such as Portobello or Cremini, are widely available in grocery stores and are less likely to have confusing dark spots. If you’re growing mushrooms at home, ensure proper conditions to minimize abnormalities. For foraged mushrooms, always cook them thoroughly, as heat can neutralize certain toxins. However, cooking will not make a toxic mushroom safe if it’s fundamentally poisonous, so accurate identification remains paramount. By combining research, caution, and practical knowledge, you can confidently enjoy mushrooms with dark spots that are naturally part of their profile.
Rehydrating Psilocybe Mushrooms: Techniques, Benefits, and Safety Tips
You may want to see also
Explore related products

Storage Tips: Proper storage in a cool, dry place can prevent dark spots from forming on mushrooms
Dark spots on mushrooms often raise concerns about their edibility, but proper storage can significantly reduce their occurrence. Mushrooms are highly perishable and sensitive to moisture, which accelerates spoilage and causes discoloration. Storing them in a cool, dry place—ideal temperature between 34°F and 38°F (1°C and 3°C)—slows enzymatic activity and microbial growth, preserving their texture and appearance. Avoid refrigeration below 32°F (0°C), as freezing temperatures can damage cell walls, leading to dark spots even after thawing.
To maximize shelf life, store mushrooms in their original packaging or a paper bag, which allows air circulation while absorbing excess moisture. Plastic bags trap humidity, fostering mold and discoloration. For longer storage, place a paper towel in the bag to absorb moisture, replacing it daily if necessary. If using airtight containers, add a layer of paper towel at the bottom to prevent condensation. These simple steps maintain optimal conditions, minimizing the risk of dark spots and ensuring mushrooms remain safe to eat.
Comparing storage methods reveals the importance of airflow and dryness. While plastic wrap or sealed containers might seem protective, they create a humid environment that accelerates decay. In contrast, paper bags or loosely covered containers mimic natural conditions, allowing mushrooms to "breathe" without drying out. This balance is critical, as overly dry storage can cause shriveling, while excess moisture invites spoilage. The key is creating a microclimate that mimics a cool, shaded forest floor—mushrooms’ natural habitat.
For those who purchase mushrooms in bulk, freezing is an alternative but requires blanching to preserve texture. However, freezing often results in darker spots post-thaw due to cell damage, making proper cool, dry storage the superior method for maintaining freshness. By prioritizing ventilation and temperature control, even home cooks can extend mushroom life by up to a week, reducing waste and ensuring every cap and stem remains appetizing.
In summary, dark spots on mushrooms are largely preventable with mindful storage practices. A cool, dry environment, coupled with breathable packaging, safeguards their quality without compromising taste or safety. While minor discoloration may still occur, it’s rarely a sign of toxicity—but why risk it when prevention is this straightforward? Master these storage tips, and your mushrooms will stay spotless and ready for any recipe.
Can Dogs Safely Eat Store-Bought Mushrooms? A Pet Owner's Guide
You may want to see also

Preparation Advice: Trim or discard dark spots before cooking to minimize potential risks and improve taste
Dark spots on mushrooms, often a result of bruising or aging, can signal changes in texture, flavor, and safety. While not all dark spots indicate spoilage, they may suggest the mushroom is past its prime or has been mishandled. Trimming or discarding these areas before cooking is a practical step to ensure both safety and culinary quality. This simple precaution removes potentially compromised tissue, reducing the risk of consuming off-flavors or harmful microorganisms that thrive in damaged areas.
From a culinary perspective, dark spots can detract from the overall taste and appearance of a dish. Bruised areas often become mushy or develop a bitter taste, which can overpower the delicate, earthy flavor of mushrooms. By carefully removing these spots, you preserve the mushroom’s natural texture and enhance its ability to absorb flavors from other ingredients. For example, when preparing sautéed mushrooms, trimming dark areas ensures each piece cooks evenly and maintains a firm, appetizing bite.
The process of trimming is straightforward but requires attention to detail. Use a small paring knife or kitchen shears to cut away discolored sections, leaving only healthy, unblemished flesh. For larger mushrooms like portobellos, slice off the affected area layer by layer until the remaining tissue is firm and light in color. Smaller mushrooms, such as button or cremini, may need to be partially or entirely discarded if the dark spots are extensive. Always inspect mushrooms thoroughly, as spots can sometimes be hidden beneath the cap or along the stem.
While trimming dark spots is generally safe, it’s essential to recognize when a mushroom is beyond salvage. If the spots are widespread, accompanied by a slimy texture, or emit a foul odor, discard the mushroom entirely. These signs indicate advanced spoilage or mold growth, which can pose health risks even after cooking. For those with weakened immune systems, children, or the elderly, this caution is particularly important, as they may be more susceptible to foodborne illnesses.
Incorporating this preparation advice into your cooking routine not only elevates the quality of your dishes but also reinforces a mindful approach to food safety. By treating mushrooms with care and scrutiny, you ensure that every meal is both delicious and safe. Whether you’re crafting a creamy mushroom risotto or a simple omelet, taking the time to trim dark spots is a small step with significant culinary and health benefits.
Mushrooms in Chicken Noodle Soup: A Flavorful Twist to Try?
You may want to see also
Frequently asked questions
It depends. Dark spots on mushrooms can be caused by bruising, aging, or natural pigmentation. If the mushroom is otherwise firm and smells fresh, it’s likely safe to eat. However, if the spots are accompanied by sliminess, mold, or an off odor, discard the mushroom.
Not always. Dark spots can result from handling or natural processes, but they can also indicate spoilage if the mushroom is soft, slimy, or has a foul smell. When in doubt, trust your senses and err on the side of caution.
Dark spots alone are not inherently dangerous, but if they are a sign of spoilage or mold, consuming the mushroom could cause foodborne illness. Always inspect the mushroom thoroughly and avoid eating any that show signs of decay.